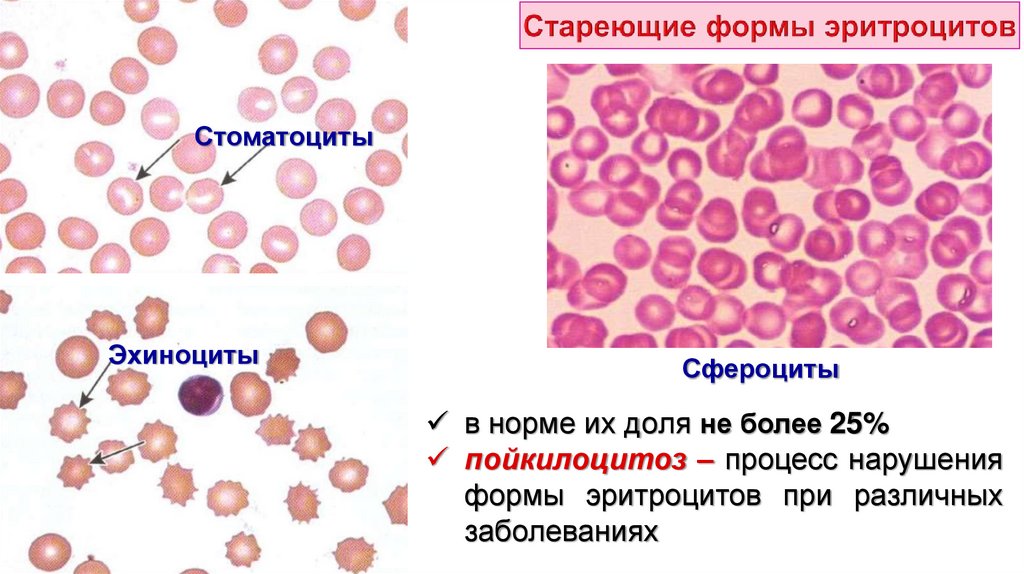
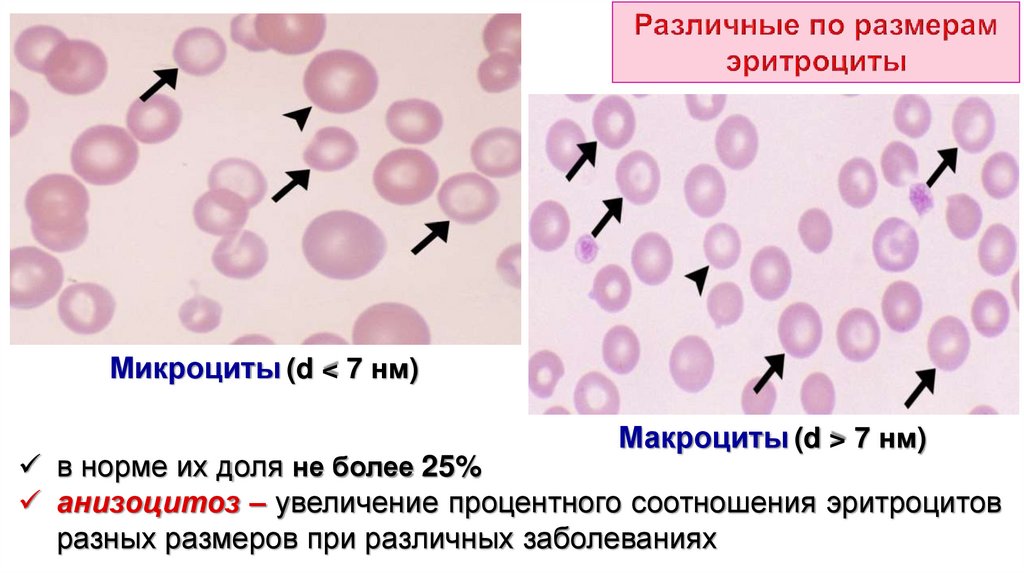
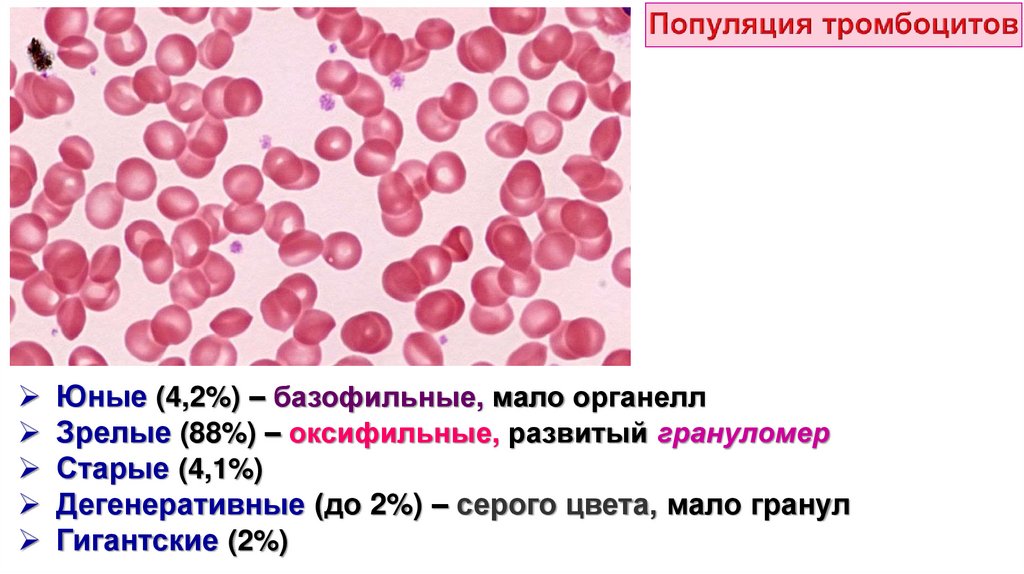
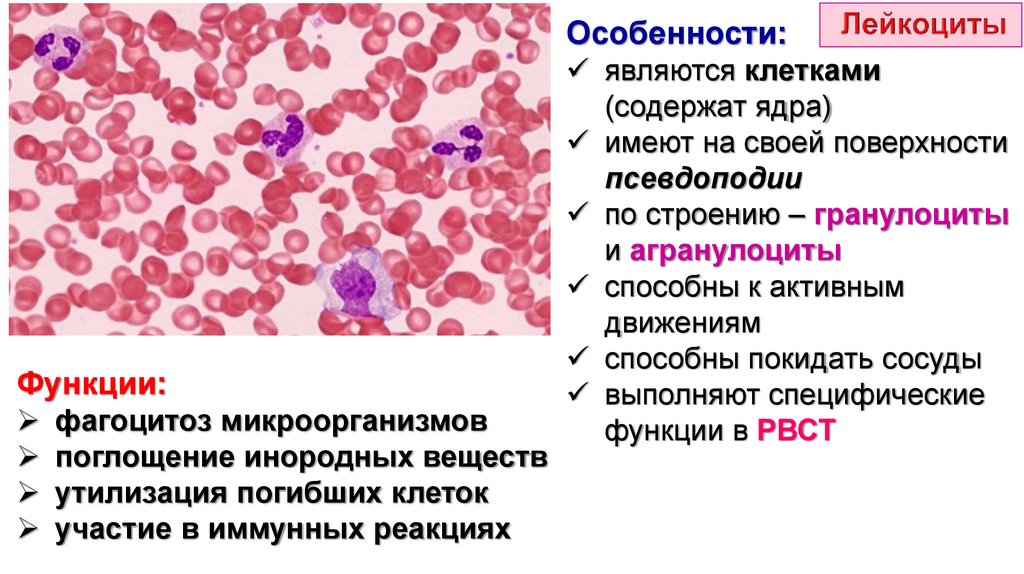
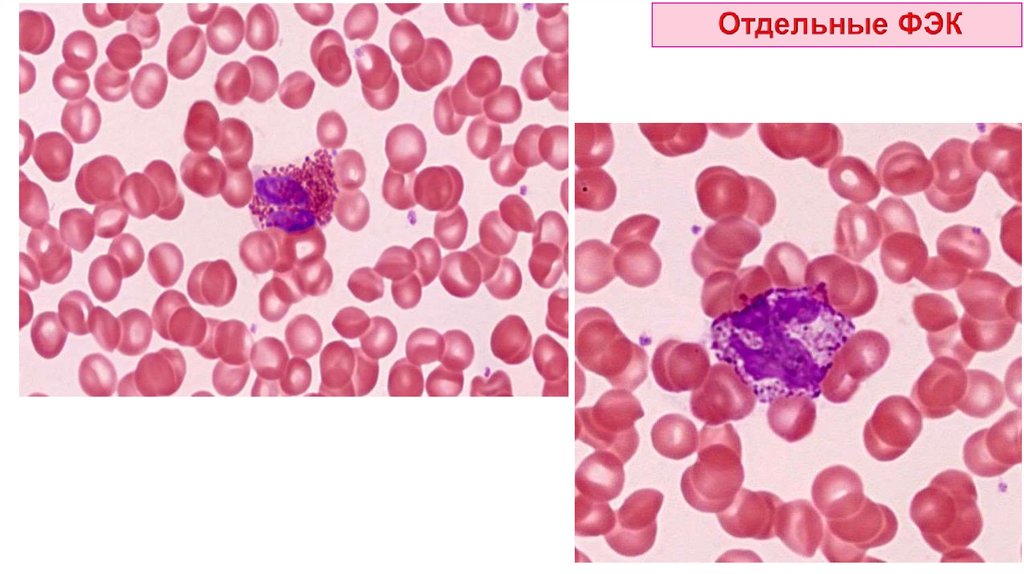
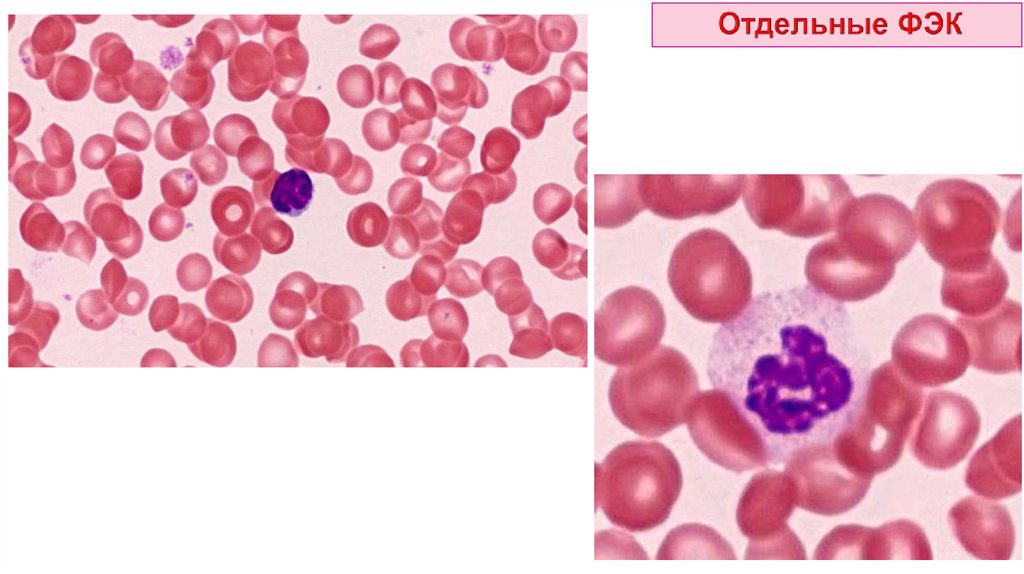
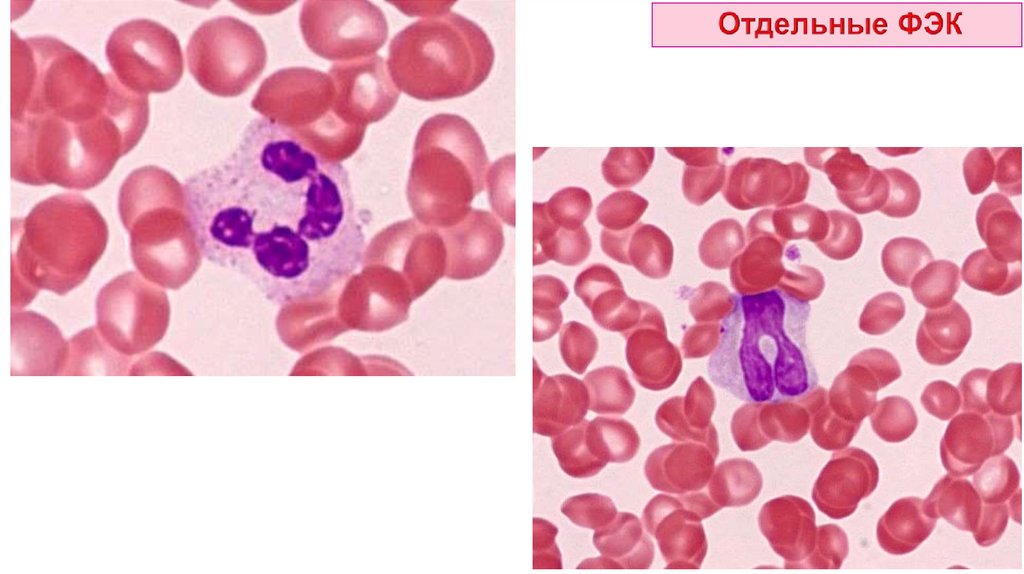
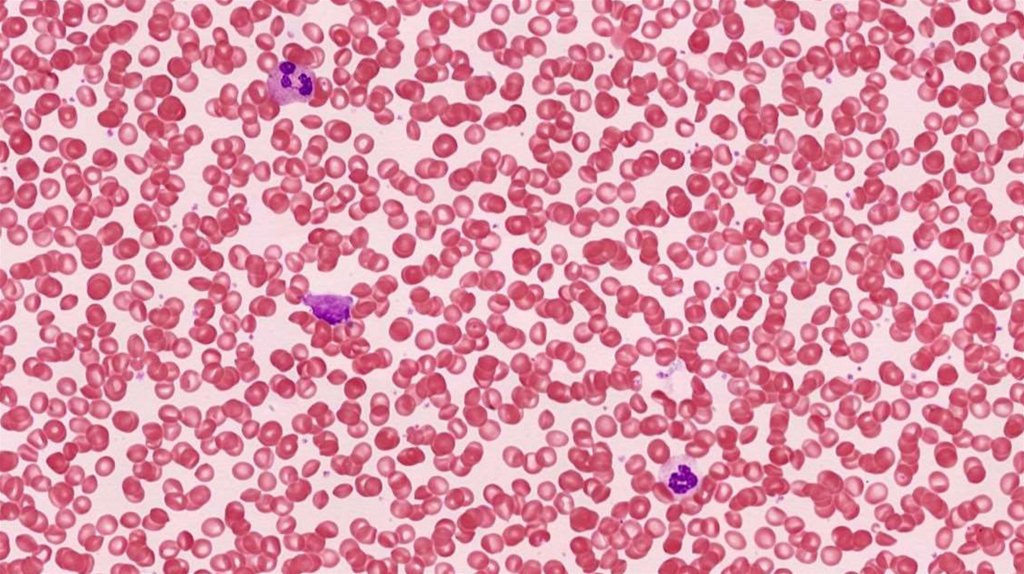
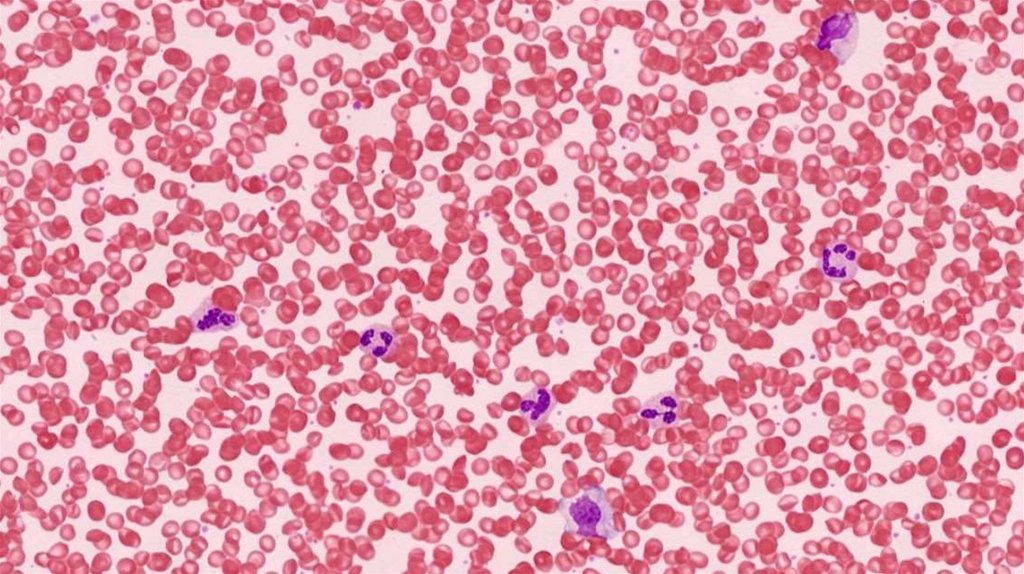
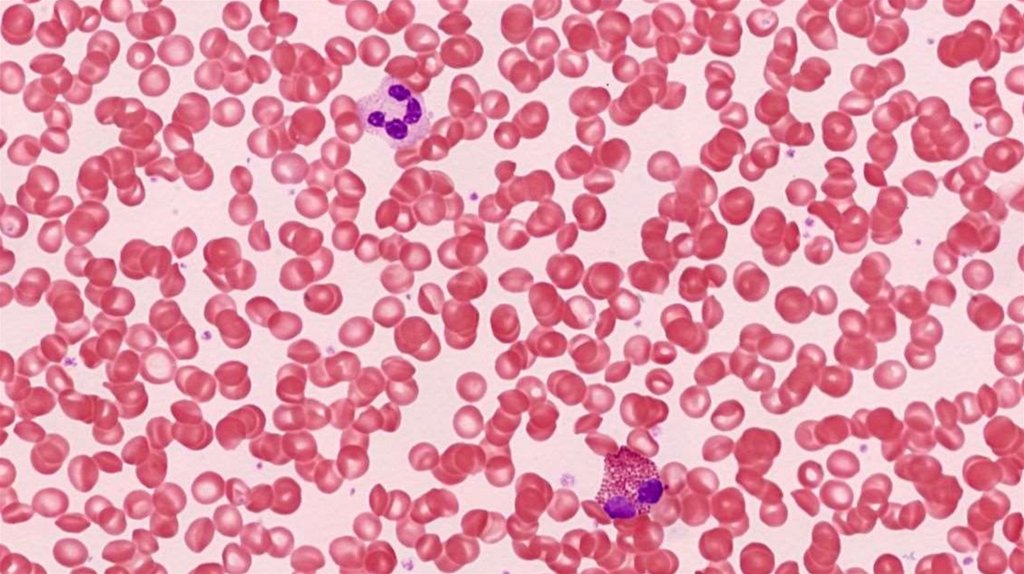
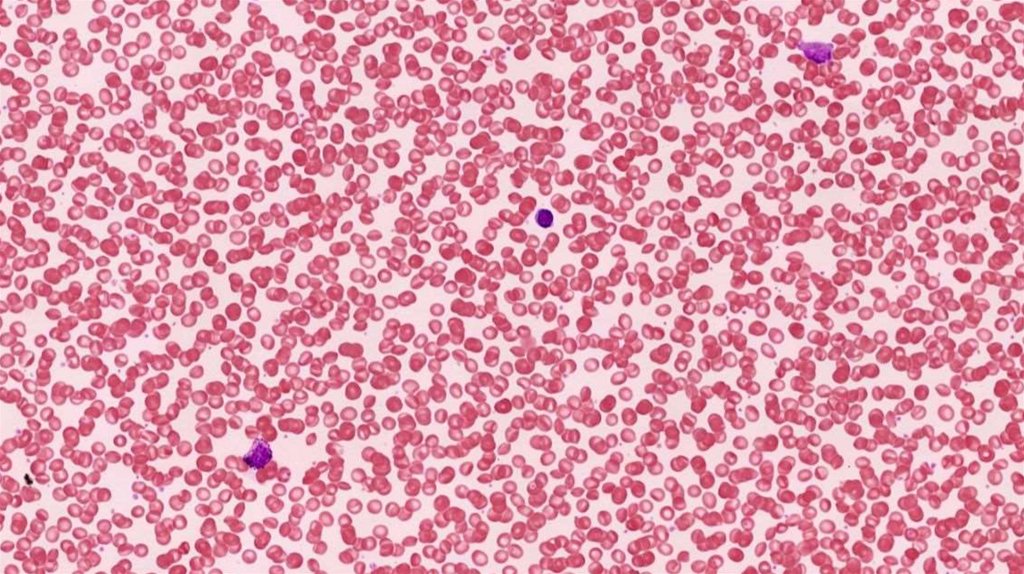
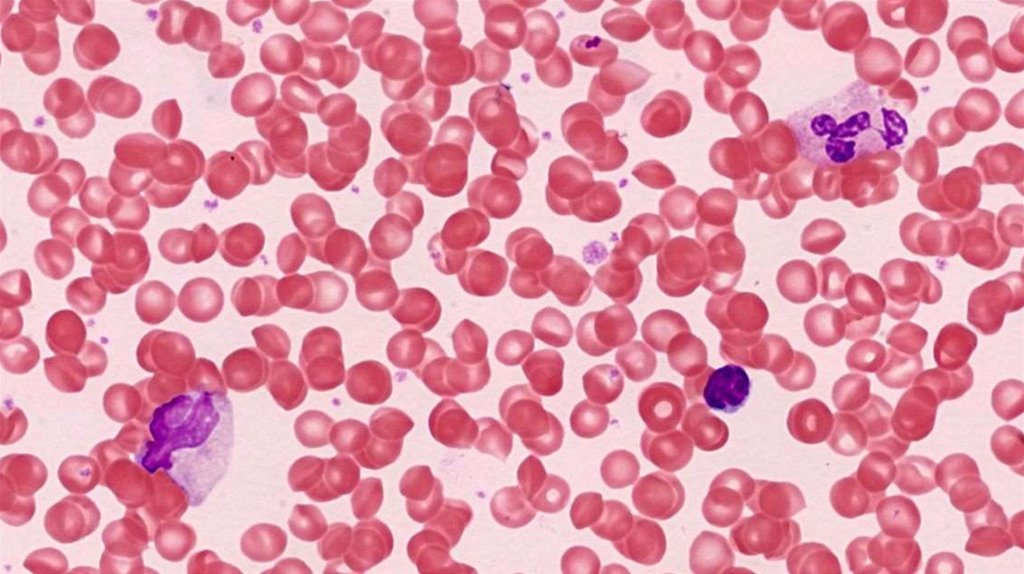
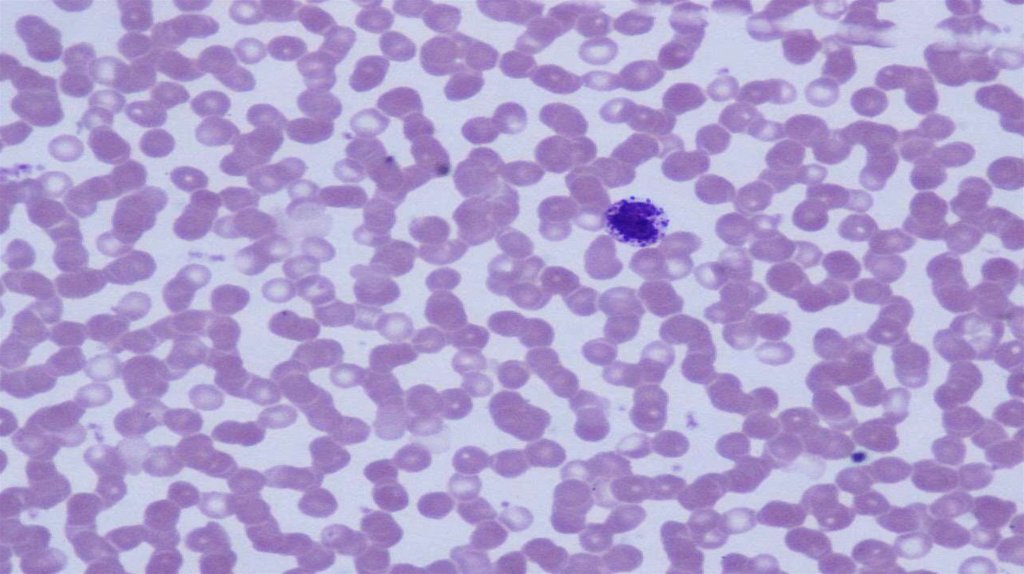
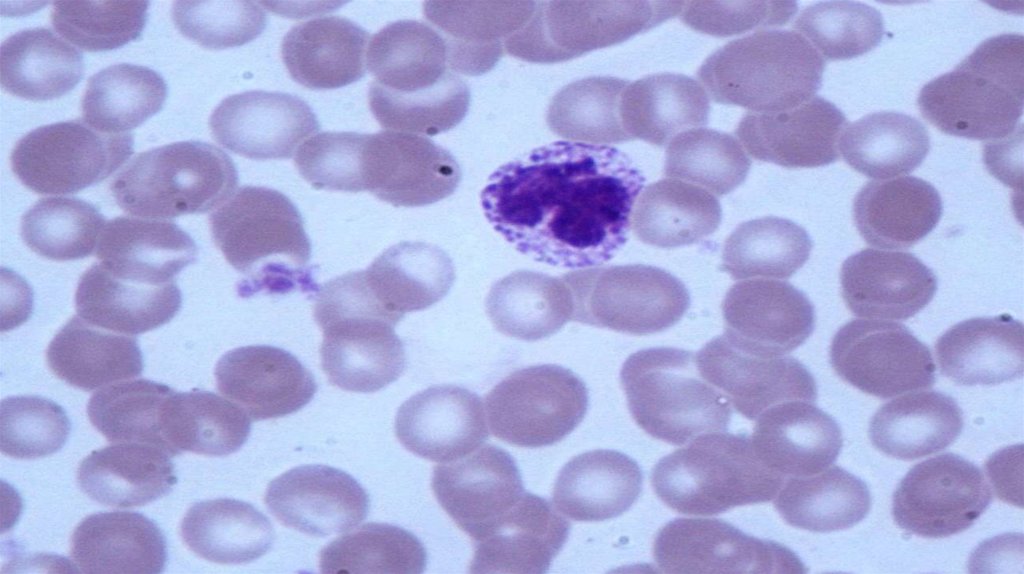

Похожие презентации:
Кровь и лимфа
1.
2.
Системакрови
Кровь
Лимфа
Органы
кроветворения и
иммунопоэза
обеспечивает постоянство состава и количества циркулирующей
крови
поддерживает динамическое равновесие, сбалансированность и
относительную стабильность всех элементов крови
подчиняется общим законам нейрогуморальной регуляции
имеет мезенхимное происхождение (кроме тимуса)
3.
КровьФорменные
элементы
Межклеточное
вещество
(эритроциты, лейкоциты,
тромбоциты)
(плазма)
40-45%
55-60%
Гематокрит – отношение объёма форменных элементов
ко всему объёму крови.
4.
Вода (90 - 93%)Сухое вещество (7 - 10%):
Низкомолекулярные вещества (1,5 - 2%)
ионы, глюкоза, мочевина
Белки (6,6 - 8,5%) – более 200 видов:
5 фракций: альбумины; α1, α2, β1, β2, γ- глобулины; фибриноген
почти все образуются в печени
(γ-глобулины синтезируются плазмоцитами)
Транспортируемые плазмой вещества:
питательные вещества, всосавшиеся в ЖКТ
промежуточные продукты метаболизма (лактат, пируват)
гормоны
конечные продукты обмена (мочевина, мочевая кислота, билирубин,
креатинин, аммиак)
5.
Альбумины (около 60% от всех белков плазмы):поддержание онкотического давления крови
обепечивают вязкость крови
эндогенный резерв аминокислот
транспортируют билирубин, холестерол, жирные кислоты, соли
желчных кислот, ряд лекарственных препаратов (аспирин,
сульфаниламиды, дикумарол и т.д.)
Глобулины (около 20-30% от всех белков плазмы):
• α и β-глобулины – транспортируют липиды, гормоны, витамины,
микроэлементы
• γ-глобулины (иммуноглобулины, интерфероны) – участвуют в
защитных реакциях
Фибриноген (4-8% от всех белков плазмы):
• обеспечивает свертывание крови, превращаясь в нерастворимый
белок фибрин
NB! Плазма крови, лишенная фибриногена, – сыворотка.
6.
Форменные элементы крови – это различные по строению ифункциям клетки и постклеточные структуры.
Эритроциты (↑ - эритроцитоз; ↓ - эритроцитопения)
Лейкоциты (↑ - лейкоцитоз; ↓ - лейкоцитопения)
Тромбоциты (↑ - тромбоцитоз; ↓ - тромбоцитопения)
Общие признаки:
• подвижность (активная или пассивная)
• отсутствие полярности
• непродолжительность жизненного цикла (для большинства)
• отрицательно заряженная поверхность (препятствует их
слипанию и прикреплению к эндотелию сосудов)
7.
Гемограмма–
совокупность
абсолютных
значений количества форменных элементов в
расчёте на 1 л крови.
Показатель
Эритроциты
Значения
Женщина
Мужчина
(3,7 - 4,9) • 10¹² /л (3,9 - 5,1) • 10¹² /л
Гемоглобин
120 - 140 г/л
130 - 160 г/л
Гематокрит
0,36 - 0,42
0,40 - 0,49
СОЭ
2-15 мм/ч
1-10 мм/ч
Тромбоциты
(150 - 450) • 10⁹ /л
Лейкоциты
(4 - 9) • 10⁹ /л
8.
Гемограмма–
совокупность
абсолютных
значений количества форменных элементов в
расчёте на 1 л крови.
Показатель
Значение
н/р (1 день)
1 год
5 лет
Эритроциты (4,5 - 7,6) • 10¹² /л (3,5 - 4,8) • 10¹² /л (3,5 - 4,7) • 10¹² /л
Гемоглобин
180 - 240 г/л
120 - 140 г/л
120 - 140 г/л
Ретикулоциты
0,3 - 5 %
0,3 - 1,5 %
0,4 - 1 %
Тромбоциты (180 - 490) • 10⁹ /л (150 - 450) • 10⁹ /л (150 - 450) • 10⁹ /л
Лейкоциты
(9 - 25) • 10⁹ /л
(5,5 - 12) • 10⁹ /л
(4 - 9,5) • 10⁹ /л
9.
Функции:Транспортная – основная функция крови:
• защитная – транспорт клеток и веществ для обеспечения
генетического гомеостаза, защиты от чужеродных
метаболитов, свёртывания крови
• дыхательная – доставка O₂ и удаление CO₂
• трофическая – транспорт питательных веществ
• выделительная – доставка продуктов обмена к органам
выделения
• регуляторная – транспорт гормонов, БАВ, макро- и
микроэлементов
Гомеостатическая (поддержание постоянства химических
и физических констант внутренней среды организма)
10.
Лимфа – жидкая ткань внутреннейсреды, состоящая из циркулирующих
по системе лимфатических сосудов
форменных элементов и жидкой
плазмы.
Функции:
• трофическая – транспорт липидов
и других питательных веществ для
пластических целей
• защитная – транспорт иммуноглобулинов, иммунных комплексов,
чужеродных частиц
• регуляторная – транспорт гормонов, БАВ
• дренажная – отток тканевой жидкости и её перераспределение в
организме
11.
Форменные элементы:преимущественно лимфоциты
иногда встречаются другие виды
лейкоцитов
Плазма:
образуется из тканевой жидкости
близка по составу к плазме крови:
(более низкое содержание белка,
более высокое содержание липидов)
NB! Состав оттекающей лимфы
динамичен и характеризует
особенности обмена в органах
(поступление инородных частиц,
бактерий, опухолевых клеток)
12.
7 - 8 мкм1,9 мкм
0,8 мкм
безъядерные постклеточные структуры с
оксифильной цитоплазмой, лишенной органелл
форма двояковогнутого диска – дискоциты (75-80%)
общая площадь всех эритроцитов – 3800 м²
диаметр (7-8 мкм)
нормоциты
толщина по периферии (1,9 мкм), по центру (0,8 мкм) (не менее
объем (85-90 мкм³)
75%)
продолжительность жизни – 120 суток
13.
СтоматоцитыЭхиноциты
Сфероциты
в норме их доля не более 25%
пойкилоцитоз – процесс нарушения
формы эритроцитов при различных
заболеваниях
14.
Микроциты (d < 7 нм)Макроциты (d > 7 нм)
в норме их доля не более 25%
анизоцитоз – увеличение процентного соотношения эритроцитов
разных размеров при различных заболеваниях
15.
предшественники эритроцитовв норме – до 1% (у детей –
несколько больше)
повышение их содержания
наблюдается при кровопотерях,
гемолитических анемиях,
подъёме на высоту
уменьшение их содержания
наблюдается при угнетении
эритропоэза
выявляются бриллиантовым крезиловым голубым
при окраске выявляется ретикулофиламентозная субстанция
(остатки Комплекса Гольджи, митохондрии, небольшое число
рибосом, центриоль)
16.
несётантигены
резус
фактора
(Rh)
и
детерминанты
групп
крови
имеет
многочисленные
рецепторы к различным
веществам и транспортные
белки (в т.ч. ионные насосы)
содержит 15 главных белков (более 60% – гликофорины, спектрин,
анкирин, белки полосы 3 и 4.1)
обладает гибкостью, эластичностью, устойчивостью к действию
повреждающих факторов, прочностью (за счёт непредельных
углеводородов и белков цитоскелета)
17.
Гликофорин:Белок полосы 3:
трансмембранный
гликопротеин
содержит остатки
сиаловой кислоты
(обеспечивают
выраженный
отрицательный заряд)
выполняет рецепторную
функцию
трансмембранный гликопротеин
участвует в обмене CO₂, транспортируя HCO₃‾ и Cl ‾
18.
Спектрин:Белок полосы 4.1:
основной белок цитоскелета
состоит из α и β-цепей
формирует гибкую сеть на
внутренней поверхности
плазмалеммы
вместе с актином образует
сетевидную
подмембранную структуру
связывает спектрин, актин с гликофорином
Анкирин:
связывает спектрин с белком полосы 3
19.
Состав:Вода (66%)
Сухой остаток (33%) – гемоглобин, глюкоза, АТФ, ферменты
Гемоглобин:
α₁ - цепь
2+
Fe
гем
β₁ - цепь
белок с четвертичной структурой
β₂ - цепь
состоит из 4 цепей белка глобина
(синтез
осуществляется
на
полисомах
и
контролируется
генами 11 и 16 хромомосом)
каждая белковая цепь связана с
небелковой частью – гемом
(синтезируется в митохондриях
эритробластов)
гем – порфирин, комплексно
связанный с Fe 2+ , который
присоединяет и отделяет O₂
α₂ - цепь
20.
Типы гемоглобина(различаются строением цепей глобина и сродством к кислороду):
HbE (эмбриональный):
• синтезируется в эмбриональном желточном
несколько недель после оплодотворения
• состоит из 2 α- и 2 ε-цепей
• замещается на фетальный гемоглобин
мешке
через
HbF (фетальный):
появляется во второй половине эмбриогенеза
синтезируется в печени и костном мозге плода до его рождения
состоит из 2 α- и 2 γ-цепей
доля в эритроцитах взрослого человека (0,5-1%)
HbA1
• основной тип гемоглобина в эритроцитах взрослого человека (90-95%)
• состоит из 2 α- и 2 β-цепей
• доля в эритроцитах новорожденного (85%)
21.
Типы гемоглобина:HbA2:
• состоит из 2 α- и 2 δ-цепей
• доля в эритроцитах взрослого человека (около 2,5%)
HbA1c (гликозилированный):
• доля в эритроцитах взрослого человека (около 3-5%)
• определение HbA1с является тестом по оценке и мониторингу
уровня глюкозы у пациентов с сахарным диабетом
• при диабете его доля может составлять от 6 до 15%
HbS:
мутантная форма
образуется в результате точечной мутации гена, кодирующего HbA
приводит к развитию серповидно-клеточной анемии
в 6-ом положении β-цепи глобина глутаминовая кислота заменена
на валин
22.
Производные гемоглобина:оксигемоглобин (HbO2)
карбгемоглобин (HbCO2)
карбоксигемоглобин (HbCO)
3+
метгемоглобин (met-Hb) – содержит Fe
Транспорт O2:
• в растворенном виде
• в связанном с гемоглобином виде
(1г Hb – 1,34 мл O2)
Транспорт СO2:
• в растворенном виде (6-7%)
• в форме карбгемоглобина (2-10%)
• в виде бикарбонатов (>80%)
23.
Выполняются только впросвете сосуда
дыхательная
регуляторная и защитная
транспорт веществ, связанных
с гликокаликсом мембраны
(АК, токсины, лекарственные
вещества)
поддержание буферных
свойств крови
24.
Изменения при старенииэритроцитов:
• ↓ количества сиаловых кислот в плазмалемме → агглютинация
• ↓ активности ферментов гликолиза → ↓ АТФ → ↑ проницаемости
плазмалеммы для Na+ → гемолиз
• ↓ активности ферментов, поддерживающих гемоглобин в
восстановленном состоянии
• нарушение целостности цитоскелета →
изменение формы (сфероциты и т.п.)
Стареющие эритроциты:
• не могут проходить через щели
синусоидных капилляров селезёнки
• поглощаются макрофагами
25.
GPIb/IX26.
безъядерные постклеточные структурыпо форме – дисковидные,
двояковыпуклые
диаметр (2-4 мкм)
толщина (0,5-0,75 мкм)
объём (5-10 мкм³)
в норме – 2/3 тромбоцитов циркулирует
в кровотоке, а 1/3 – находится
в красной пульпе селезёнки
продолжительность жизни – 9-10 суток
27.
Плазмалемма:снаружи покрыта толстым слоем
гликокаликса (участвует в агрегации
тромбоцитов)
содержит
интегральные
белки:
антигены групп крови, рецепторы
адгезии и агрегации
Цитоплазма:
содержит органеллы в большом
количестве (ЭПС, митохондрии, КГ,
рибосомы, гранулы гликогена)
представлена гиаломером (светлая
периферическая часть) и
грануломером (центральная часть,
содержащая гранулы)
28.
Гиаломер содержит:хорошо развитый цитоскелет:
• пучки
циркулярных
микротрубочек
(поддерживают форму тромбоцитов)
• сократительные белки (актин, миозин,
гельзолин и др.) – участвуют в уменьшении
тромбоцита и ретракции тромба
две системы канальцев:
• открытая (краевые мембранные канальцы) –
участвуют в секреции содержимого α-гранул
и захвате факторов свёртывания
• закрытая (мембранные трубочки с
электронно-плотным содержимым) –
2+
содержат пероксидазу, накапливают Ca ,
вырабатывают простагландины
29.
Грануломер содержит:α-гранулы (самые крупные, с умеренно
плотным матриксом) :
• факторы
свёртывания
(фибриноген,
фактор Виллебранда, проакцелерин и др.)
• факторы роста (тромбоцитарный, ФР-β)
• гликопротеины (участвующие в адгезии
тромбоцитов)
δ-гранулы (имеют уплотнённую сердцевину):
• гистамин, серотонин, АТФ, Са2+
λ-гранулы (лизосомы):
• гидролитические ферменты
• АТФ-аза
микропероксисомы:
• пероксидаза
30.
Выполняются только в просветесосуда
участие в реакциях свёртывания крови:
• первичный гемостаз (механизм остановки кровотечения при
повреждении капилляров)
• вторичный гемостаз (каскадный ферментативный процесс, в ходе
которого происходит взаимодействие и последовательная активация
сериновых протеиназ на фосфолипидных матрицах, заканчивающийся
превращением фибриногена в фибрин)
синтез ангиогенных факторов (для заживления поврежденной
сосудистой стенки)
участие в реакциях воспаления
обеспечение нормального функционирования эндотелия
участие в обмене биогенных аминов
31.
Юные (4,2%) – базофильные, мало органеллЗрелые (88%) – оксифильные, развитый грануломер
Старые (4,1%)
Дегенеративные (до 2%) – серого цвета, мало гранул
Гигантские (2%)
32.
Тромбоцит:1 – α-гранулы
2 – глыбки гликогена
3 – ЭПС (закрытая
система канальцев)
4 – митохондрии
5 – вакуоли
6 – отростки тромбоцита
33.
Тромбоцит:1 – гиаломер
2 – грануломер
3 – пучки микротрубочек
4 – краевые мембранные канальцы
5 – α - гранулы
6 – δ - гранулы
7 – включения гликогена
34.
Особенности:Функции:
фагоцитоз микроорганизмов
поглощение инородных веществ
утилизация погибших клеток
участие в иммунных реакциях
являются клетками
(содержат ядра)
имеют на своей поверхности
псевдоподии
по строению – гранулоциты
и агранулоциты
способны к активным
движениям
способны покидать сосуды
выполняют специфические
функции в РВСТ
35.
Цитокины,селектины,
хемокины,
интегрины –
молекулы
иммунной
системы
36.
А – нейтрофилБ – эозинофил
В – базофил
Особенности:
имеют сегментированные ядра
форма ядер меняется по мере созревания клеток
изменения структуры ядер необратимы
содержат неспецифические, или азурофильные гранулы (лизосомы с
литическими ферментами) – присущи всем гранулоцитам
• содержат специфические гранулы (определяют функциональные
возможности клеток) – окрашиваются разными красителями
37.
А – лимфоцитБ – моноцит
Особенности:
• имеют НЕсегментированные ядра
• НЕ содержат специфических гранул
• заканчивают свою дифференцировку в тканях
38.
Лейкоцитарнаяформула
–
процентное
содержание разных видов лейкоцитов.
9
Лейкоциты: (4 - 9) • 10 /л
Нейтрофилы
Базофилы Эозинофилы Моноциты Лимфоциты
60-75%
ю
п
с
0603-5%
0,5%
65%
0-1%
1-5%
6-8%
20-40%
Сдвиги лейкоцитарной формулы:
• влево (увеличение доли юных и палочкоядерных нейтрофилов) –
кровопотеря, появление очага воспаления
• вправо (увеличение доли сегментоядерных нейтрофилов) –
угнетение гемопоэза
39.
ВозрастНейтрофилы
Лимфоциты
новорожденные
65%
25%
45%
45%
4-е сутки
1 - 2 года
4 года
1-й физиологический перекрест
25%
65%
45%
45%
2-й физиологический перекрест
14 -15 лет
65%
25%
взрослые
65-75%
20-40%
40.
Долялейкоцитов, %
Возраст, лет
41.
Особенности:диаметр в мазке (9-12 мкм)
диаметр в тканях (до 20 мкм)
образуются в ККМ в течение 7 суток,
через 4 суток выходят в кровоток
находятся в крови 8-12 суток
продолжительность жизни в тканях –
5-9 суток
9
(2,0 – 5,5) • 10 /л
↑ - нейтрофилия
↓ - нетропения
42.
3 пула:резервный (зрелые нейтрофилы костного мозга)
циркулирующий (переносимые кровью клетки)
пограничный (связанные с эндотелием сосудов клетки)
43.
Юный нейтрофил(ядро бобовидной
формы)
Палочкоядерный
нейтрофил
(ядро в виде
изогнутой палочки)
Сегментоядерный
нейтрофил
(ядро состоит из
3-5 сегментов)
44.
Неспецифические(азурофильные) гранулы
Цитоплазма:
хорошо развитый цитоскелет
органеллы общего назначения
развиты слабо
имеются включения гликогена
и липидов
содержит 2 типа гранул:
• азурофильные (80%) – крупные;
появляются первыми в процессе
развития
• нейтрофильные (20%) – мелкие;
розово-фиолетовые (окрашиваются
как основными, так и кислыми
Периферическая зона
красителями)
без органелл
Сегменты
ядра
Специфические
гранулы
Тельце Барра
Псевдоподии
45.
образует гипохлорит-ион ClO‾миелопероксидаза
(сильный окислитель)
разрушает бактериальную стенку
Неспецифические лизоцим
расщепляют органические полимеры
(азурофильные) гидролитические
ферменты
на мономеры
гранулы
обладают микробицидной
антимикробные белки
активностью
лизоцим
щелочная фосфатаза
пероксидаза
Специфические лактоферрин
(нейтрофильные)
коллагеназа
гранулы
разрушает бактериальную стенку
разрушают ДНК микробной клетки
обеспечивает склеивание бактерий
• разрушает коллагеновые волокна,
• облегчает экстравазацию и
перемещение нейтрофила в РВСТ
фосфолипаза
разрушает мембраны клеток
цитокины (есть во всех привлекают других лейкоцитов в очаг
лейкоцитах)
воспаления
46.
Нейтрофил:1 – сегменты ядра
2 – перемычка между
сегментами
3 – специфические гранулы
4 – ЭПС
5 – митохондрии
47.
41
5
2
4
1
3
5
Нейтрофил:
1 – сегменты ядра (3-5)
2 – перемычка между
сегментами
3 – тельце Барра
4 – азурофильные гранулы
5 – специфические гранулы
48.
фагоцитоз микробов(микрофаги):
• сопровождается респираторным
взрывом
• происходит формирование гноя
уничтожение микроорганизмов
без поглощения (внеклеточно)
разрушение и переваривание
тканевого детрита
синтез цитокинов, кейлонов,
пирогенных веществ,
интерферона
49.
Особенности:диаметр в мазке (11-12 мкм)
диаметр в капле крови (около 9 мкм)
образуются в ККМ
находятся в крови 1-2 суток
продолжительность жизни в тканях –
4-16 суток
9
(0,01 – 0,08) • 10 /л
↑ - базофилия
↓ - базопения
50.
ПсевдоподииЯдро (дольчатое с 2
сегментами или S-образное)
Плазмалемма (содержит
рецепторы к IgE)
Цитоплазма:
Неспецифические
(азурофильные)
гранулы
Ядро
имеются все органеллы и
включения гликогена
содержит 2 типа гранул:
• азурофильные
Специфические (немногочисленны)
гранулы
• базофильные – мелкие; тёмновишнёвые (окрашиваются
метахроматически),
«маскируют» ядро
51.
гистаминСпецифические гепарин
(базофильные)
гранулы
серотонин
SRS-A (медленно
реагирующая субстанция
анафилаксии)
хемотаксические
факторы эозинофилов и
нейтрофилов
• повышает проницаемость
основного вещества
соединительной ткани
• увеличивает просвет и
проницаемость сосудов
• способствует развитию отёка
• препятствует свёртыванию крови
• обеспечивает
метахроматическую окраску
влияет на проницаемость
сосудистой стенки
вызывает стойкое сокращение ГМК
стенки бронхов
привлекают остальных гранулоцитов
в очаг воспаления
52.
Базофил:1 – дольчатое ядро
2 – специфические гранулы
3 – глыбки гликогена
53.
11
3
2
1
4
Базофил:
1 – специфические гранулы
2 – ядро
3 – митохондрия
4 – включения гликогена
54.
Дегрануляция – выделение базофиломсвоих
специфических
гранул
при
связывании с IgE или на изменение
химизма окружающей среды.
регуляция деятельности внутренних
органов путём влияния на:
• сократимость ГМК бронхов, сосудов,
органов ЖКТ
• секрецию желез
инициация воспалительных реакций
обеспечение развития аллергических
реакций:
• генерализованные (анафилактический шок)
• местные (крапивница, бронхиальная астма)
55.
Особенности:диаметр в мазке (12-17 мкм)
образуются в ККМ
находятся в крови 3-8 часов
продолжительность жизни в тканях –
8-12 суток
количество в крови подвержено
суточным изменениям (max – ночью,
min – утром)
9
(0,04 – 0,45) • 10 /л
↑ - эозинофилия
↓ - эозинопения
56.
ЯдроЯдро (2-3 сегмента)
Цитоплазма:
имеются включения гликогена,
липидов
умеренно развиты органеллы
содержит 2 типа гранул:
• азурофильные
(немногочисленны)
• эозинофильные – содержат
кристаллоидные структуры;
окрашиваются эозином
Неспецифические
(азурофильные) гранулы
Специфические
гранулы
57.
главный основныйбелок MPB
Специфические эозинофильный
(эозинофильные) катионный белок
гранулы
гистаминаза
арилсульфатаза
эозинофильная
пероксидаза
эозинофильный
нейротоксин
белки-перфорины
• образует кристаллоид
• обсулавливает эозинофилию гранул
• обладает мощным
антигельминтным и
антипаразитарным эффектом
• вызывает высвобождение гистамина
из базофилов
• оказывает токсическое действие на
простейших и гельминтов
• нейтрализует гепарин
разрушает гистамин
разрушает анафилаксин
оказывает антимикробное и
антипаразитарное действие в
присутствие пероксида водорода
токсичен для клеток нервной системы
гельминтов
повреждают оболочки клеток
58.
12
1
4
3
3
1
1
4
5
Эозинофил:
1 – кристаллоид
2 – неспецифические гранулы
3 – ядро
4 – митохондрия
5 – включения гликогена
59.
антигельминтное и антимикробное действиеограничивают распространение аллергической и воспалительной
реакции
способны к фагоцитозу бактерий, спор грибов, комплексов АГ-АТ
60.
Особенности:диаметр в мазке (10-20 мкм) – самые
крупные
развиваются в ККМ в течение 2-3
суток
находятся в крови 2-4 суток
продолжительность жизни в тканях –
до 1 месяца
тканевая форма - МАКРОФАГ
9
(0,2 – 0,8) • 10 /л
↑ - моноцитоз
↓ - моноцитопения
61.
Ядро:расположено эксцентрично
полиморфное или бобовидное
хроматин неравномерно
конденсирован
содержит одно или несколько
ядрышек
Цитоплазма:
голубовато-серая
содержит азурофильные гранулы
(мелкие лизосомы)
хорошо развиты органеллы
62.
фагоцитоз:• неспецифический
(поглощение
микроорганизмов;
опухолевых,
стареющих и погибающих клеток;
постклеточных структур)
• специфический (поглощение
комплексов АГ-АТ)
АГ-презентация (АПК)
стимулируют пролиферацию и
дифференцировку лимфоцитов
образуют моноцитарномакрофагическую систему
63.
56
3
4
7
2
1
2
Моноцит:
1 – ядро
2 – лизосомы
3 – рибосомы
4 – грЭПС
5 – вакуоли
6 – митохондрии
7 – комплекс Гольджи
64.
Особенности:диаметр в мазке (5-13 мкм)
развиваются в ККМ
продолжительность жизни в тканях –
несколько часов - несколько лет
(70% лимфоцитов – долгоживущие)
циркулирует в кровотоке – 2%,
находятся в тканях – 98%
9
(1,2 – 3,6) • 10 /л
↑ - лимфоцитоз
↓ - лимфопения
65.
Малые (4,5-6 мкм) – преобладают (95%)!!!светлый
тёмный
Средние
(7-10 мкм)
Большие – характерны для детей
(10-18 мкм)
66.
Строение:Ядро:
расположено эксцентрично
занимает большую часть клетки
содержит плотно упакованный
хроматин
Цитоплазма:
содержит азурофильные гранулы
(мелкие лизосомы)
богата рибосомами
Роль: обеспечение реакций
иммунитета
67.
42
1
2
3
1
4
Лимфоцит:
1 – ядро
2 – рибосомы
3 – грЭПС
4 – митохондрии
68.
Клеточный иммунитет – это защита от чужеродныхклеток, трансплантата, собственных мутировавших
клеток (т.е. клеток, несущих чужеродный антиген).
Суть: лимфоцит уничтожает клетку (носителя антигена)
69.
Гуморальныйиммунитет
–
это защита от
растворенных во внутренней среде антигенов (продуктов
жизнедеятельности бактерий, метаболитов, аллергенов,
токсинов, чужеродных сывороточных белков).
Суть: антитела связываются с антигенами и нейтрализуют их
70.
ЛимфоцитыТ-лимфоциты
(65-75%)
NK
(5-20%)
B-лимфоциты
(15-20%)
отвечают за клеточный
иммунитет
регулируют гуморальный
иммунитет
Виды:
• Т-хелперы
• Т-супрессоры
• Т-киллеры (цитотоксические)
• Т-клетки памяти
отвечают за
гуморальный
иммунитет
Виды:
• Плазмоциты
• В-клетки памяти
71.
Т-хелперы – участвуют в регуляции КИО и ГИО путём секрециицитокинов (интерлейкинов, интерферона), которые влияют на
пролиферацию других лимфоцитов, миграцию макрофагов.
Т-хелперы I типа (воспалительные):
• синтезируют ПРОвоспалительные цитокины (ИЛ-1, ФНО,
γ-интерферон)
• осуществляют киллинг чужеродных клеток (путём запуска
апоптоза)
Т-хелперы II типа (хелперные):
• синтезируют ПРОТИвоспалительные цитокины (ИЛ-10),
ростовые факторы (ИЛ-4,5,6,9,13)
• усиливают образование антител
72.
Цитотоксические Т-лимфоциты – уничтожают чужеродные,собственные мутировавшие и пораженные вирусом клетки.
убивают клетки путём активации определенных генов, которые
индуцируют программированную гибель клетки (апоптоз)
секретируют белки перфорины и гранзины, что ведет к лизису
клетки
Т-супрессоры – подавляют активность других клеток иммунной
системы, останавливают развитие иммунного ответа.
Т-клетки
памяти
–
долгоживующие
клетки,
которые
формируются после первой встречи с антигеном; при повторной
встрече обеспечивают более быстрый иммунный ответ.
73.
Плазмоциты – клетки, которые в большомколичестве синтезируют антитела.
1 – ядро (колесо со
спицами)
2 – грЭПС
3 – митохондрии
4 – комплекс Гольджи
(светлый дворик)
В-клетки памяти – долгоживующие клетки, которые формируются
после первой встречи с антигеном; при повторной встрече
значительно быстрее продуцируют антитела.
74.
не имеют Т-клеточных иВ-клеточных рецепторов
способны к пролиферации
при действии цитокинов
осуществляют
антиопухолевый надзор
уничтожают пораженные
вирусом клетки
75.
76.
77.
78.
79.
80.
81.
82.
83.
84.
85.
86.
87.
88.
89.
90.
91.
92.
93.
94.
95.
96.
97.
98.
99.
100.
101.
102.
Гемопоэз – это процесс образования крови как ткани иливосстановление естественной убыли утративших способность к
делению дифференцированных форменных элементов крови.
эмбриональный
постэмбриональный
103.
Этапы:мезобластический (2-3 – 9-10 недели)
гепато-сплено-тимический
(5-6 недели – конец внутриутробного развития)
медуллярный (с 10 недели)
4
1 – желточный мешок
2 – печень
3 – красный костный мозг
4 – селезёнка
104.
источник –мезенхима стенки
жеточного мешка
формирование
кровяных островков
ИНТРАваскулярное
кроветворение
Итог: формирование 1 генерации ГСК
крупные эритробласты (мегалобласты), содержащие HbE
небольшое количество гранулоцитов
эритробласты и эритроциты дефинитивного типа (7-8 недели)
105.
1) Печень (5-6 неделя – конец эмбриогенеза):ЭКСТРАваскулярное кроветровение
мигрировавшие ГСК 1 генерации (из желточного
мешка)
мегалобласты
3) Л/У:
формирование 2 генерации ГСК
образование эритроцитов,
• дефинитивные эритроциты
гранулоцитов, мегакариоцитов
с HbF (с 7-8 недели)
(сначала)
• гранулоциты (с 10 недели)
преобладает лимфопоэз
• мегакариоциты (с 5 недели)
(с середнины эмбриогенеза)
2) Селезёнка (5-6 неделя – конец эмбриогенеза):
ЭКСТРАваскулярное кроветровение
• универсальный орган кроветворения (5 месяц)
• преобладает лимфопоэз
(к концу эмбриогенеза)
4) Тимус:
заселение УПК
Т-лимфопоэза
(7-8 неделя)
106.
Локализация – красный костный мозгначало – 10-22 недели
формирование 3 генерации ГСК
ЭКСТРАваскулярное кроветровение
• эритроциты
• лейкоциты
• мегакариоциты
• В-лимфоциты
107.
108.
Постэмбриональный гемопоэз –физиологическая регенерация крови,
обусловленная
коротким
сроком
жизни форменных элементов крови.
Миелопоэз – развитие клеток крови миелоидного ряда, (т.е.
клеток-потомков ПСК-предшественницы миелопоэза), полностью
протекающее в ККМ (эритро-, тромбо-, грануло-, моноцитопоэз)
Лимфопоэз – развитие клеток крови лифоидного ряда, (т.е.
клеток-потомков ПСК-предшественницы лимфопоэза), протекающее
в два этапа в различных органах иммунопоэза.
109.
Свойства:полипотентность
самоподдержание (не менее 50% дочерних клеток идентично
материнским)
редкость делений (связана с отсутствием ответа на факторы
дифференцировки)
низкая концентрация (в кроветворных органах 1 : 10³ , в крови 1 : 10⁴)
отсутствие дифференцировки
(имеют морфологию малого лимфоцита)
способность к рециркуляции
отсутствие чувствительности
к гемопоэтинам
110.
ПСК:КФК-ГЭММ (предшественница миелопоэза – гранулоцитов,
эритроцитов, моноцитов, мегакариоцитов)
КФК-Л (предшественница лимфопоэза)
Свойства: НЕ дифференцированы, частично детерминированы
ограниченная способность к самоподдержанию
УСК:
КФК-Эр (предшественница эритроцитов)
КФК-Гм (предшественница гранулоцитов, моноцитов)
КФК-МГЦ (предшественница мегакариоцитов)
КФК-В (предшественница В-лимфоцитов)
КФК-Т (предшественница Т-лимфоцитов)
Свойства: НЕ дифференцированы, имеют одну возможность развития,
приобретают чувствительность к гемопоэтинам
111.
Бласты:• активно пролиферируют
• обеспечивают необходимое количество зрелых клеток в
периферической крови
• начинают специфическую дифференцировку
Созревающие клетки:
• постепенно утрачивают способность к пролиферации
• окончательно дифференцируются
Зрелые клетки:
• циркулируют в периферической крови
• выполняют специфические функции
112.
Эритропоэз – процесс образования и созреванияэритроцитов, который происходит в ККМ (3-7 суток).
Проэритробласт
Оксифильный
эритробласт
Базофильный
эритробласт
Полихроматофильный
эритробласт
Ретикулоцит
Эритроциты
113.
Особенности протекания:• постепенное уменьшение размеров клеток
• снижение активности пролиферации
NB! Наиболее активное деление отмечается у проэритробластов и
базофильных эритробластов
• выработка и накопление гемоглобина
• постепенное уменьшение количества и, по итогу, утрата всех
органелл и ядра (на стадии оксифильного проэритробласта)
Изменения ретикулоцит → эритроцит:
завершение сборки подмембранного комплекса
исчезновение способности к эндоцитозу
↑ содержания гемоглобина
114.
Тромбоцитопоэз – процесс образованиятромбоцитов, который протекает в ККМ (10 суток).
Мегакариобласт
Промегакариоцит
Мегакариоцит (128n)
Изменения мегакариобласт → мегакариоцит:
• увеличение размеров клеток с накоплением большого количества
гранул
• полиплоидизация ядра (до 128n)
• формирование демаркационных мембран
115.
Образованиетромбоцитов:
мегакариоцит
проталкивает часть
своей цитоплазмы в виде
отростков) в щели
капилляров ККМ
фрагменты цитоплазмы
отделяются в виде
тромбоцитов
(за счет демаркационных
мембран)
116.
Гранулоцитопоэз – процесс образованиягранулоцитов, который протекает в ККМ.
Миелобласт
Промиелоцит
Миелоцит нейтрофильный
Метамиелоцит
нейтрофильный (юный)
Палочкоядерный
нейтрофил
Сегментоядерный
нейтрофил
117.
Гранулоцитопоэз – процесс образованиягранулоцитов, который протекает в ККМ.
Миелобласт
Промиелоцит
Миелоцит эозинофильный
Метамиелоцит
эозинофильный (юный)
Палочкоядерный
эозинофил
Сегментоядерный
эозинофил
118.
Гранулоцитопоэз – процесс образованиягранулоцитов, который протекает в ККМ.
Миелобласт
Промиелоцит
Метамиелоцит
базофильный (юный)
Миелоцит базофильный
Сегментоядерный
базофил
119.
Особенности протекания:• снижение активности пролиферации
NB! Метамиелоцит (юный) полностью утрачивает способность к митозу!
• уменьшение размеров клеток
• накопление в клетках НЕспецифических (со стадии промиелоцита) и
специфических (со стадии миелоцита) гранул
• изменение формы ядра (округлое → овальное → бобовидное →
палочковидное → сегментированное)
Формы ядер у различных форм:
метамиелоцит (юный) – бобовидное
палочкоядерный лейкоцит – толстая изогнутая палочка без перемычек
сегментоядерный лейкоцит – состоит из нескольких сегментов
120.
Моноцитопоэз – процесс образованиямоноцитов, который протекает в ККМ (2-3 дня).
Монобласт
Промоноцит
Особенности протекания:
уменьшение размеров клеток
снижение активности пролиферации
изменение формы ядра до бобовидной
накопление в клетках азурофильных гранул
Моноцит
121.
Лимфоцитопоэз – развитие Т- и В-лимфоцитовиз ПСК-предшественницы лимфопоэза (КФК-Л).
АнтигенНЕзависимая дифференцировка:
• протекает в ККМ (для В-лимфоцитов) и в тимусе (для Т-лимфоцитов)
• происходит формирование различных рецепторов (АГ-распознающих,
хоминга, CD и т.д…)
• протекает в отсутствии антигенов (АГ)
• при созревании морфологически: уменьшение размеров клеток и ядра
Итог: выход в кровь лимфоцитов, способных распознавать АГ
Лимфобласт
Пролимфоцит
Лимфоцит
122.
Антигензависимая дифференцировка:• протекает во вторичных органах иммунопоэза (лимфатическом узле,
селезёнке, миндалинах, КАЛТ, червеобразном отростке)
• протекает в присутствии антигенов (АГ)
Этапы:
• распознавание АГ (только при наличии специфических рецепторов)
• бласттрансформация
• пролиферация
• дифференцировка
Плазмобласт
Проплазмоцит
Плазмоцит

Медицина
Медицина








